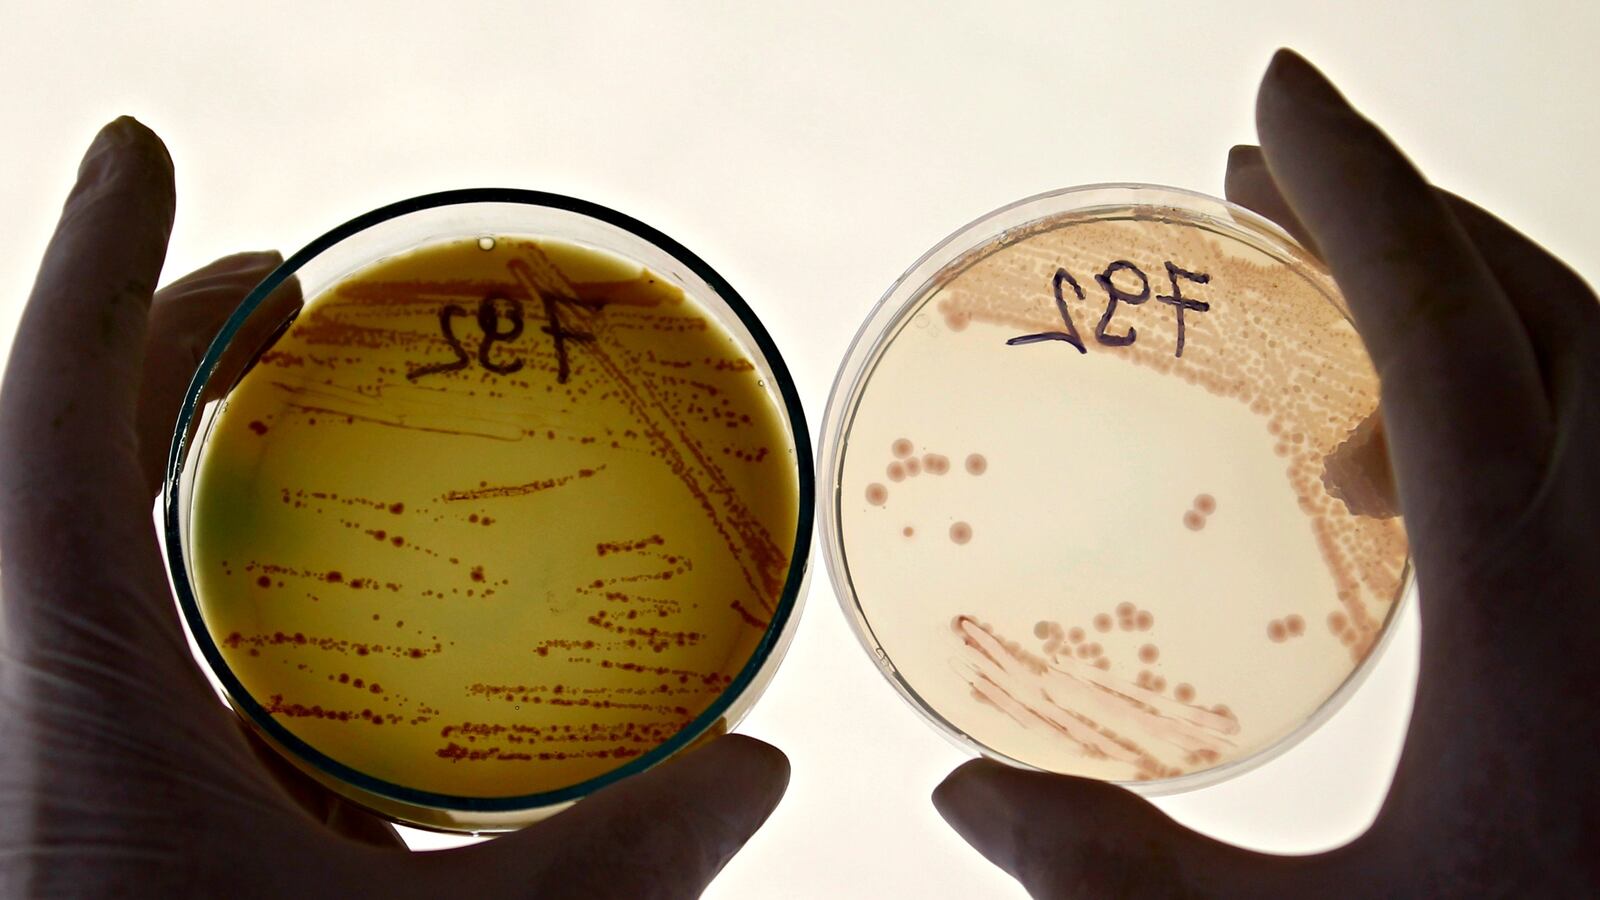
cheats/2016/05/26/antibiotic-resistant-bacteria-now-in-u-s/160526-superbug-antibiotic-cheat_bgtkzj

According to Department of Defense researchers, an antibiotic-resistant strain of the E. Coli bacteria has been detected in the urine of a 49-year-old American woman. According to a study published Thursday in Antimicrobial Agents and Chemotherapy, this particular bug is resistant to the antibiotic colistin, a "last-resort" antibiotic used to fight especially dangerous types of superbugs. Top U.S. health officials reportedly worry that the spread of this antibiotic-resistant strain could result in "the end of the road" for antibiotics.
Read it at The Washington Post